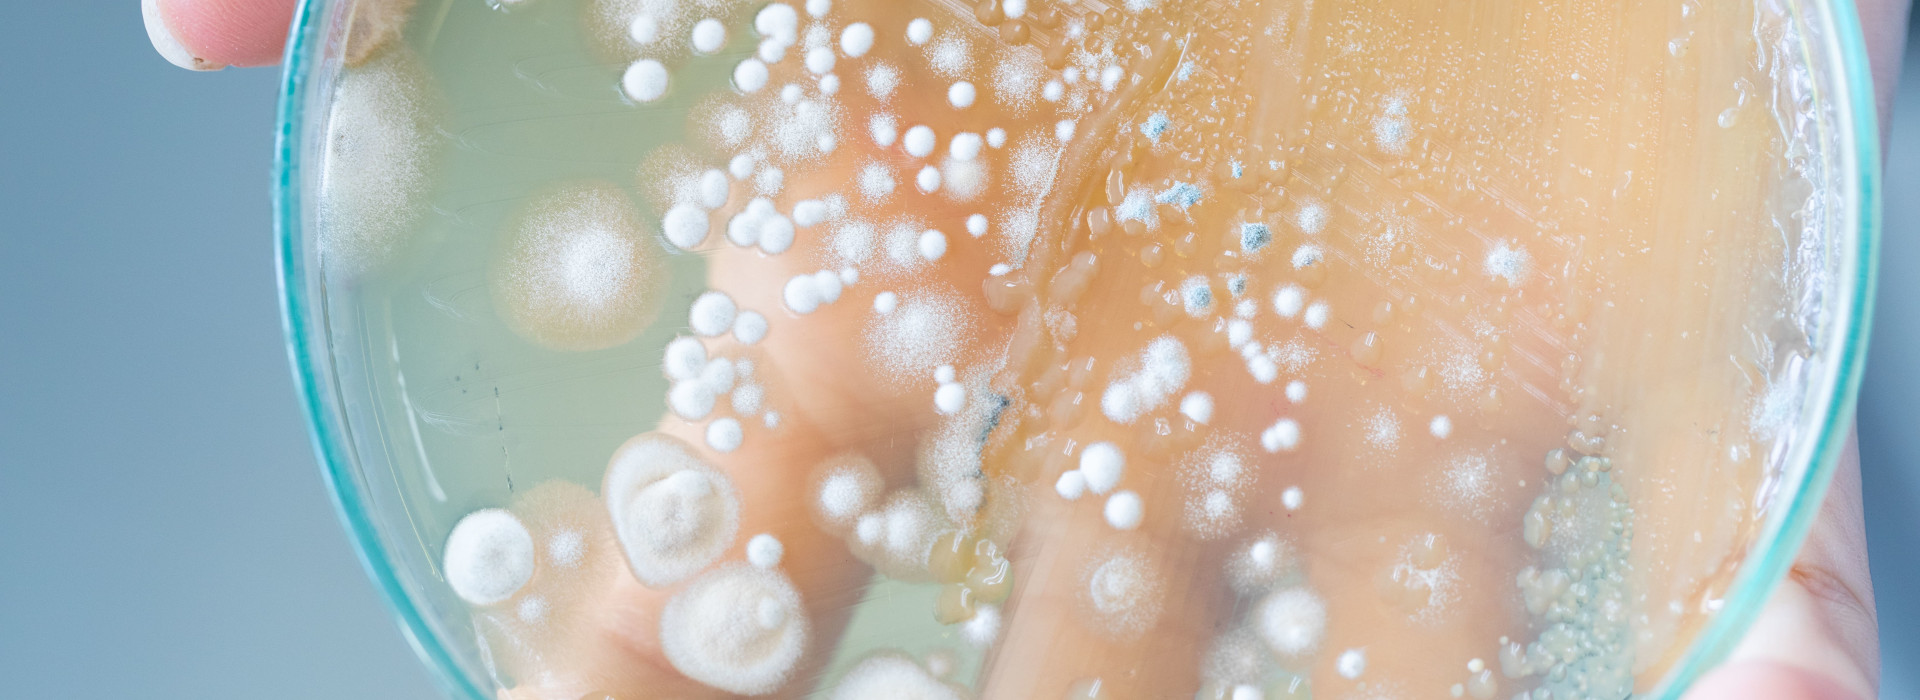

Inail e i rischi da esposizione da agenti microbiologici
Nell’Elenco degli agenti microbiologici presenti nell’ Allegato XLVI del D.Lgs. 81/2008, nel secondo gruppo di rischio sono presenti i micobatteri non tubercolari.
La trasmissione di questi microbatteri avviene per via aerea.
Più in particolare, come si legge nel documento avviene:
“a seguito dell’inalazione di aerosol (particelle liquide o solide aerodisperse) contaminato dal microrganismo presente in composti per giardinaggio, terriccio, bacini idrici naturali, impianti distribuzione acqua, soffioni doccia, umidificatori, vasche idromassaggio, serbatoi, ecc”.
L’INAIL ha approfondito questo aspetto attraverso la realizzazione di un factsheet prodotto dal Dipartimento Inail di medicina, epidemiologia, igiene del lavoro e ambientale (DIMEILA).
Il rischio di esposizione a microbatteri non tubercolari in ambienti di vita e lavoro
Questo il titolo del factsheet realizzato.
In prima istanza si legge che il genere Mycobacterium:
“è costituito da un gruppo eterogeneo di specie e sottospecie batteriche. Ad eccezione del Mycobacterium tuberculosis complex, del Mycobacterium leprae complex e di Mycobacterium ulcerans, le rimanenti specie sono complessivamente indicate come ‘micobatteri non tubercolari’ (Non Tuberculous Mycobacteria, NTM).
Lo studio indica poi un dato decisamente particolare: gli NTM sono costituiti da più di 190 specie e sottospecie ambientali.
Di queste, solo una minima parte si rivelano patogene per l’uomo.
Lo studio arriva ad una conclusione particolare: negli ultimi anni si è registrato un aumento esponenziale di casi registrati di infezioni da NTM non solo in pazienti con patologie preesistenti ma anche in soggetti sani.
Come si legge nello studio:
Si ritiene che l’aumento dei casi “possa essere attribuito a numerosi fattori tra cui la maggiore disponibilità di tecniche microbiologiche più sensibili e specifiche rispetto al passato, l’aumento del rischio di esposizione e l’ invecchiamento della popolazione”.
Incidenza della malattia e rischi occupazionali
La malattia polmonare causata da NTM in Italia è è soggetta a notifica in classe III (d.m. 15/12/1990).
Si indica però anche un altro dato di fatto particolare: la complessità della diagnosi rende molto difficile fare una diagnosi, per questo motivo l’incidenza della malattia in ambito occupazionale è, ad oggi, ampiamente sottostimato.